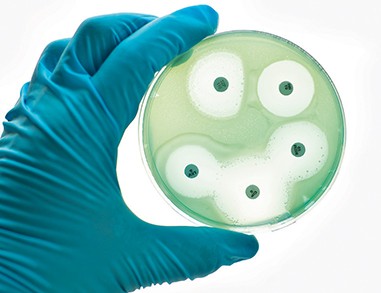
Tijdens hun tocht door de zorgketen kunnen patiënten een BRMO krijgen of verspreiden.

De kern
-
Bijzonder resistente micro-organismen (BRMO) verspreiden zich via patiënten door de zorgketen.
-
Landelijk zijn tien antibioticaresistentie-zorgnetwerken in oprichting om de keten rondom BRMO beter te organiseren.
-
De huisarts is als voorschrijver van antibiotica en hoofdbehandelaar van dragers van BRMO buiten het ziekenhuis of verpleeghuis een belangrijke schakel in deze keten.
-
Het regionale antibioticaresistentie-zorgnetwerk biedt de huisarts toegang tot de kennis en deskundigen die nodig zijn om deze schakelrol te vervullen.
Kritische blik op antibioticagebruik
Tachtig procent van de bij mensen gebruikte antibiotica wordt voorgeschreven in de eerste lijn.1 Gebruik van antibiotica leidt tot een selectie op resistente bacteriën. Dit geldt ook voor de eerstekeusantibiotica die de huisarts voorschrijft. Bij terughoudend, geïndiceerd gebruik verloopt de ontwikkeling van resistentie aanzienlijk langzamer dan bij ruimhartig en ongepast antibioticagebruik. Nederlandse huisartsen zijn in het voorschrijven van antibiotica terughoudend vergeleken met collega’s in andere landen.2 Dit is een factor die bijdraagt aan de lage resistentiepercentages in ons land. Deze verworvenheid behoeft wel onderhoud. Van Driel et al. constateren in dit nummer van Huisarts en Wetenschap terecht dat antibioticaresistentie (ABR) ook voor de huisarts een groeiend probleem is. Ook in de Nederlandse huisartsenpraktijk is nog ruimte om kritisch te kijken naar gepast antibioticagebruik.345
Om de gunstige situatie in Nederland te behouden is de minister van Volksgezondheid, Welzijn en Sport in 2015 gestart met een meerjarenplan voor de aanpak van antibioticaresistentie. Dit programma omvat meerdere pijlers, waar versterking van de aanpak van antibioticaresistentie in de zorg er een van is.6 Verbeterde samenwerking tussen de eerste lijn, de tweede lijn, de publieke gezondheidszorg en de langdurige zorg speelt hierbij een belangrijke rol. De minister zet daarom in op de vorming van regionale zorgnetwerken voor de aanpak van ABR. Bijzonder resistente micro-organismen (BRMO) bewegen zich namelijk voor een belangrijk deel door de zorgketen via patiënten. En patiënten bewegen zich voornamelijk binnen de regio. Tijdens hun tocht door de zorgketen lopen patiënten het risico op het verkrijgen of verspreiden van een BRMO.7 Samenwerking binnen de regio moet leiden tot beter overzicht van de aanwezigheid in en beweging van resistente bacteriën door de regio. In Nederland zijn daarom tien regionale zorgnetwerken in oprichting voor de aanpak van antibioticaresistentie [figuur]. Als voornaamste voorschrijver van antibiotica en hoofdbehandelaar van patiënten die buiten het ziekenhuis of het verpleeghuis drager zijn van een BRMO speelt de huisarts een belangrijke rol in dit netwerk.
De huisarts in het regionale abr-zorgnetwerk
Wanneer in het ziekenhuis is geconstateerd dat een van uw patiënten drager is van MRSA (meticillineresistente Stafylococcus aureus), ESBL (extended spectrum bètalactamase), CPE (carbapenemaseproducerende Enterobacteriaceae) of VRE (vancomycineresistente enterokok) zal men uw patiënt en u hierover informeren. Deze melding kan verschillende vragen oproepen. Mag uw patiënt op kraambezoek bij een pasgeboren kleinkind? Welke preventieve maatregelen moeten de medewerkers van de thuiszorg en de mantelzorgers nemen? Welke infectiepreventiemaatregelen zijn nodig bij een huisbezoek?
De deskundigen infectiepreventie en de arts-microbioloog in het ziekenhuis die zich in deze materie heeft gespecialiseerd beschikken over de kennis om deze vragen te beantwoorden. Dankzij de activiteiten van het antibioticaresistentie-zorgnetwerk leert u deze vraagbaken kennen en kunt u hen makkelijker bereiken wanneer u hen nodig heeft. Als huisarts weet u immers niet alles, maar kunt wel toegang krijgen tot de juiste kennis.
Ook Nederlandse huisartsen moeten kritisch blijven kijken naar gepast antibioticagebruik
Daarnaast werkt het antibioticaresistentie-zorgnetwerk aan deskundigheidsbevordering voor de eerste lijn. Zo komt er landelijk bijvoorbeeld een antibiotic stewardship-programma voor de eerste lijn dat via de regionale zorgnetwerken toegankelijk wordt. Met dit programma worden in de regio onder andere nascholingsmogelijkheden, contactpersonen en promotiematerialen zichtbaar gemaakt.
Taken abr-zorgnetwerk
De ABR-zorgnetwerken hebben verschillende basistaken, die elk netwerk op een eigen wijze invult. De basistaken vormen samen een coherent, regionaal antibioticaresistentie-preventie- en bestrijdingsbeleid, dat meerdere domeinen omvat, zoals de curatieve zorg, de langdurige zorg en de publieke gezondheidszorg. De basistaken richten zich op:
-
het in beeld brengen van regionale risico’s en het betrekken van zorginstellingen bij de beheersing hiervan;
-
surveillance en vroege detectie van BRMO, transparantie faciliteren en communiceren over de aanwezigheid van BRMO in de regio;
-
inzicht krijgen in infectiepreventiebeleid en waar mogelijk uniformeren van dat beleid in de regio;
-
antibiotic stewardship in de gehele zorgketen. Voor de eerste lijn is een pilot in uitvoering die zich richt op het leveren van spiegelinformatie (hoe doet mijn praktijk het ten opzichte van vergelijkbare professionals?) en de ontwikkeling van deskundigheidsbevordering, passend in bestaand kwaliteitsbeleid in de huisartspraktijk.
In 2017 is gestart met het opzetten van de structuur van de tien regionale antibioticaresistentie-zorgnetwerken. In 2018 gaan in alle netwerken diverse activiteiten van start. Uw regionale kwartiermaker kan u hierover informeren. Voor de eerste lijn zijn activiteiten op het gebied van antibiotic stewardship, deskundigheidsbevordering en verbetering van de overdracht van patiënten vanuit zorginstellingen te verwachten. Doordat u als huisarts een centrale rol hebt in de zorgketen is uw deelname nodig om de aanpak van antibioticaresistentie in deze keten te versterken.
Literatuur
- 1.↲De Greeff SC, Mouton JW. NethMap 2017: consumption of antimicrobial agents and antimicrobial resistance among medically important bacteria in the Netherlands. RIVM Rapport 2017-0056. DOI 10.21945/RIVM-2017-0056.
- 2.↲European Centre for Disease Prevention and Control. Summary of the latest data on antibiotic consumption in the European Union. Geraadpleegd op 22 november 2017. . ecdc.europa.eu/sites/portal/files/documents/EAAD_ESAC-Net_Summary2017.pdf
- 3.↲Ivanovska V, Hek K, Mantel-Teeuwisse AK, Leufkens HGM, Van Dijk L. Age-specific Antibiotic Prescribing and adherence to guidelines in pediatric patients in primary care. Pediatr Infect Dis J 2018;37(3)218-23.
- 4.↲Van der Velden AW, Kuyvenhoven MM, Verheij TJ. Improving antibiotic prescribing quality by an intervention embedded in the primary care practice accreditation: the ARTI4 randomized trial. J Antimicrob Chemother 2016;71:257-63.
- 5.↲Cals JW, Butler CC, Hopstaken RM, Hood K, Dinant GJ. Effect of point of care testing for C reactive protein and training in communication skills on antibiotic use in lower respiratory tract infections: cluster randomised trial. BMJ 2009;338:b1374.
- 6.↲Schippers EI, Van Rijn MJ, Dijksma AM, Mansveld WJ. Kamerbrief over aanpak antibioticaresistentie. Kamerbrief 76152-136545-PG; 24 juni 2015.
- 7.↲Donker T, Wallinga J, Grundmann H. Patient referral patterns and the spread of hospital-acquired infections through national health care Networks. PLoS Comput Biol 2010;6:e1000715.
Reacties (1)
Text for comment 975
- Login om te reageren